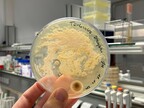

Navigation
Detail
Bakterienkultur mit Antibiotika, Ingwer und Knoblauch

Urheber:
Stefanie Müller-Kröckel
Bildnummer:
P17987
Auflösung:
1200x1600
Format:
PNG
Quelle:
https://www.schulportal-thueringen.de/pixiothek/detail?tspi=P17987
Kurzbeschreibung:
Das Bild zeigt eine Agarplatte, die mit einer Bakterienkultur bestrichen wurde. In den Bereichen 1 - 6 befinden sich Antibiotika, Ingwer und Knoblauch (zum Beispiel 1 - Ampicillin, 3 - Steptomycin, 5 - Knoblauch, 6 - Ingwer). Der sogenannte Hemmhof (Kreis um den betreffenden Bereich) ist bei Knoblauch am größten, was dessen antibakterielle Wirkung verdeutlicht.
Entstanden ist das Bild im Zuge der Ausbildung zum Biologielaboranten/ zur Biologielaborantin an der Uni Jena. Es gelten die Nutzungsbedingungen der Mediothek und Pixiothek.
Verwandte Bilder (Auswahl)

Zitronen-Ingwer-Minze-Limonade
(2848x4288)

Knoblauch
(2048x2048)
Verwandte Medien (Auswahl)

Lernort Wochenmarkt: Welc...
(öffentlich) Ein medienpä...
Online-Medium
(2018)

Unser Obst
(öffentlich) Poster und Ar...
Online-Medium
(2011)

3 Minuten Infos: Obst
(öffentlich)
Online-Medium
(2011)

Lernort: Hotspot Artenvie...
(öffentlich)
Lernort
(2026)

Gesund mit Obst & Gemüse
(öffentlich) Flipcharts ...
Online-Medium
(2012)

Warenkunde Obst
(öffentlich) Information...
Online-Medium
(2010)

Wie Städte grüner werden
(öffentlich) Unterrichts...
Online-Medium
(2017)

Entdecke das Land - Die klei...
(öffentlich)
Online-Medium
(2014)

Apfel ist nicht gleich Apfel
(öffentlich) Unterrichts...
Online-Medium
(2017)

Gärtnern in der Stadt
(öffentlich) Unterrichts...
Online-Medium
(2017)